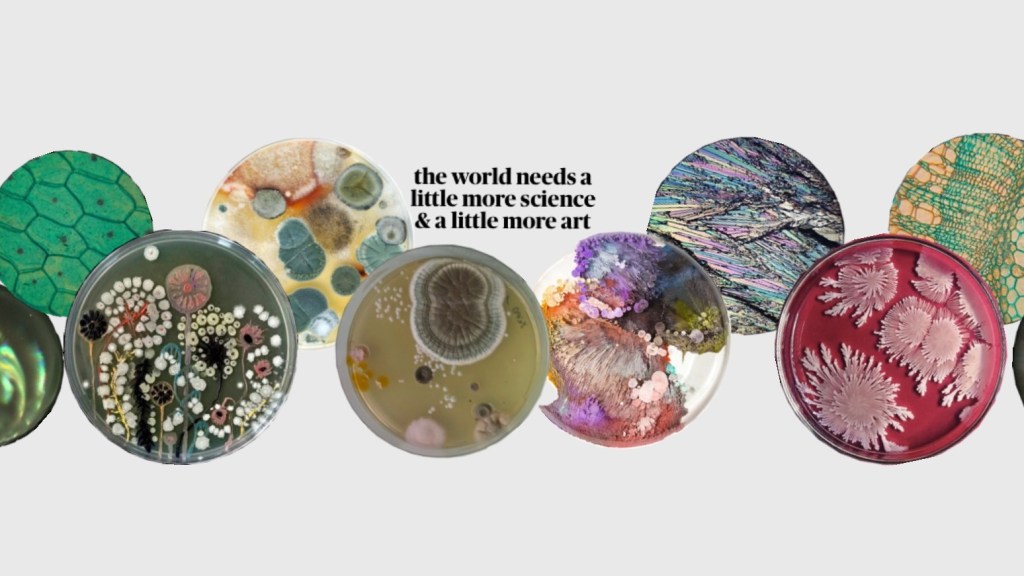

About me
Hi my name is Nunu and I’m currently a Biomedical Science Student who is undergoing their placement year with the NHS as a Trainee Biomedical Scientist!
I created this blog with the intention (or maybe the hope) of helping fellow students prepare for placement. Believe me when I say that I was NOT prepared at all for how difficult it is to secure a placement despite all the warning from previous students.